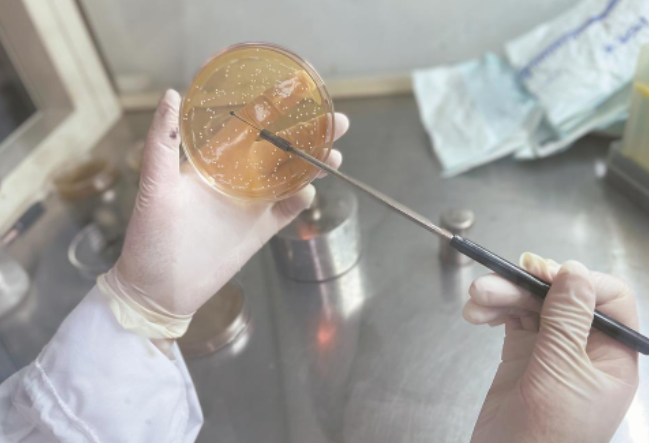

一株菌“跨界” 产销研“破圈”
|
官雪芳正在制作BXM2菌制剂,这项技术年底有望投产。
在平板上对微生物菌落进行分离培养。
厦门元之道生物科技有限公司生产车间里的全自动酵素发酵生产线 东南网4月18日报道(福建日报记者 林霞 文/图) 福建省农业科学院农业工程技术研究所副研究员官雪芳在实验室里,尝试采用最低成本帮助果农解决百香果保鲜难题时,不承想竟“遇到”了一株神奇的植物乳杆菌。 这一发现,更意外破解了一家公司的困境。 日前,福建省农业科学院与厦门元之道生物科技有限公司共建的“功能益生菌发酵技术示范基地”揭牌。这是继一年前,前者将“一株植物乳杆菌及其应用”权属转化给后者,并共同推进“益生菌选育及产品开发”项目后,双方再次开启的深度合作模式。 科学家与企业家如何进一步打破“围墙”,实现更好“相逢”?答案或许就在这株神奇的植物乳杆菌BXM2当中。 延保,糖渍百香果 三明市将乐县被誉为“中国深呼吸第一城”,其森林覆盖率为我省之最,孕育出清新自然的空气、福泽深厚的土地。 绿意盎然中,果农杨伯忠嗅到了商机,在百香果种植上颇有心经的他,于2017年陆续承包了60亩大棚,种起享有“果汁之王”“幸福之果”等美誉的百香果。 2017年夏季,科特派官雪芳踏足将乐时,跟随老杨来到偌大的仓库里。放眼望去,圆润饱满的果实堆满仓,但仔细一看,竟有不少次果。“有的是外表不佳、形状小的,还有的是放置时间长、快坏掉的。”工人们边挑拣边说。 “这些次果占比高达20%。”一旁的老杨无奈道出原因,“百香果果期长,每几天就有一小批果子成熟,无法批量采摘。尴尬的是,将乐地处偏僻,运输成本高,只能拒绝散而小的订单。果子放仓库囤积,超过7~10天,就要被淘汰了。” 类似的情况,官雪芳也在龙岩、南平等地听果农诉过苦。迈入电商网络时代,传统水果批发销售系统受到极大的挑战,单一输送往批发市场的水果销量逐年下滑。 “水果种植地基本处于山区偏远地区,加之网络信号差、文化水平限制等因素,部分果农并不适合走电商的销售渠道。”官雪芳在调查中发现,贮藏、加工能力弱,次果率高等综合因素导致很多水果严重滞销腐烂,同时,销售体系不健全、价格低下,则对果农及地区经济产生严重影响。 如何保存更多新鲜的水果,让次果也有处可去?“解决之道,在于对百香果产业的加工技术进行研发,提升产品的附加值,增加百香果消费渠道。”官雪芳说。 带着调查发现的问题,官雪芳回到了福建省农业科学院营养科学与工程实验室。在微生物菌种选育、发酵产品开发及菌制剂研制等方面有10余年经验的她,很快有了研究思路。 通常情况下,盐腌、糖渍是大部分小农户保存食品的不二选择。“能造成微生物的高渗状态,夺取微生物体内的水分,即使菌体原生质脱水收缩并与细胞膜脱离而死亡,从而延长食品的保质期。”官雪芳说。 百香果肉使用蜂蜜进行保鲜也较为常见。但问题在于,加多少蜂蜜是最优的选择,保藏过程中百香果肉的营养价值是否会发生变化? 在与农业工程技术研究所相关负责人讨论好方案后,分别按2∶1、1∶1、1∶2等比例,官雪芳将百香果肉与蜂蜜混合,放到37℃恒温箱,准备做果肉保藏和品质变化规律特征分析实验。第7天时,她观察、品尝了第一批样品后,敏锐地发现蜂蜜与百香果以大于1∶1的比例混合后的样品口味醇香浓厚,并非是百香果或蜂蜜原本的口味。 “一定存在特殊的微生物,对混合物产生了作用。”直觉告诉官雪芳,或许是某一类益生菌。 研究,摸透这株菌 操作台上,官雪芳取定量的百香果肉与蜂蜜混合物加入到灭菌的生理盐水中,对其进行梯度稀释,最后再将稀释液涂抹在各种含不同培养基的平板上进行微生物的培养,完成相关步骤后,等待这些小生命繁殖成各个小菌落。 按官雪芳的经验,她需要等平板上长出来形状各异、颜色不一的菌落,进行观察、对比后,再挑选出可能是益生菌的菌落,进行下一步分析。 拿出平板后,她愣住了:板上白茫茫一片,似是只有一种菌属,好像事先经过纯化一样,一个个均一的小菌落呈乳白色、不透明状。 显微镜之下初步验证了官雪芳的猜测,确实都是均一的杆状的革兰氏阳性菌。运用分子生物学技术手段,通过对菌株进行双基因鉴定、API生理生化分析及扫描电镜观察,最终鉴定它为植物乳杆菌。 大自然的菌大致可以分为三种,分别是益生菌、致病菌、条件致病菌。“前者对人体健康有帮助,后两者一个是会使人体生病,另一个俗称‘墙头草’,寄居在人体一定部位,在正常情况下不致病,当机体平衡状态被破坏时可引起疾病。”官雪芳说。 益生菌可以平衡肠道的pH值,促进体内菌群平衡。 关于肠道微生物,有一个占位理论。“假设肠道里面有100个位置,其中50个是益生菌,另50个是致病菌。我们摄入益生菌是去抢致病菌的位置的,抢的位置越多,益生菌占比越大,致病菌致病的可能性越小。”官雪芳解释道。 那么,她所找的这株植物乳杆菌,又有怎样的功能呢? 官雪芳将其制成菌种母液,进行了致病菌的抑菌能力测试,结果显示,相关发酵液对变异链球菌、中间普氏菌、金黄色葡萄球菌、大肠杆菌、宋内氏志贺细菌、奇异变形杆菌、鼠伤寒沙门氏菌、单核细胞增生李斯特菌等均有较好的抑菌效果。 找到宝了!“说明它对大部分致病细菌有很好的抑制作用。”官雪芳将其保存并命名为BXM2,并开发出发酵生产百香果汁的最适发酵工艺。 为了令实验更严谨,官雪芳还尝试在杀菌、未杀菌的百香果肉与蜂蜜混合液中,分别接种BXM2,发现均能发酵成功,并产生良好的风味特征。“通常,在百香果肉中,BXM2与其他微生物存在竞争关系,果肉在多种微生物作用下容易腐坏,BXM2也不易被发现;但在糖渍环境下,绝大部分益生菌已经失去了生存能力,BXM2则不然,因此其锋芒毕露。”官雪芳说。 有意思的是,BXM2能以百香果肉为原料发酵生产百香果发酵果汁,令其达到一个微妙的发酵状态,因而在口感上更为醇香浓厚,这也为发酵果汁的生产及开发提供新的发酵菌源。 官雪芳还将这株菌应用在桑葚、菠萝、猕猴桃等多种水果中,发现与百香果肉发酵有着异曲同工之妙。 再次见到杨伯忠时,官雪芳让他品尝了新开发的百香果发酵果汁。老杨对这款果汁很感兴趣,但果农没有生产许可证。“若您要彻底解决百香果次果耗损率太高这一问题,还是需要找到合适的代加工厂。”她给老杨支了招。 2019年9月,官雪芳向国家知识产权局申请“一株植物乳杆菌及其应用”发明专利,2年后,官雪芳收到了专利授权书。 应用,产研深度融 当官雪芳申请“一株植物乳杆菌及其应用”发明专利时,厦门元之道生物科技有限公司总工程师赵大洲忙着建造公司的智造中心。 该公司于2015年成立,集研发、生产、加工、销售、服务为一体,专注于以发酵萃取植物营养素。2020年底,公司买下新的工厂,瞄准菌种选育、微生物功能评价、发酵制剂、生物制药等生物技术全球重大研究课题方向。 赵大洲的心里一直有个过不去的坎儿:发酵萃取植物营养素,最关键的是菌种,菌种被视为生物发酵产业的“芯片”。一直以来,公司发酵菌种要从台湾地区或丹麦、美国等地进口,在这一关键技术上屡屡受制于人。“且不论国际市场上益生菌价格昂贵、起伏不定,公司要真正朝着‘高精尖’发展,必须解决‘卡脖子’问题,首先要做到以自主科技赋能产品升级。” 也因此,赵大洲花了几年时间,在国家知识产权局官网上深挖,寻找合适的发明专利,但一直无果。 2021年底,“一株植物乳杆菌及其应用”发明专利出来后,赵大洲辗转联系上了官雪芳,开口就是:“您的这款专利有转让的意愿吗?” 多次接触了解后,双方达成了共识。厦门元之道生物科技有限公司得到了“一株植物乳杆菌及其应用”的转让权,双方还签订了为期5年的关于“菌种选育与产品开发”的技术委托开发合同,围绕益生菌选育、产品开发及菌制剂开发等方面开展工作。今年3月,“一株植物乳杆菌及其应用”成果转化签约仪式举办,同时,福建省农业科学院“功能益生菌发酵技术科技示范基地”揭牌,围绕创新目标协同发力。 近日,记者走进厦门元之道生物科技有限公司生产车间,车间生产过程完全透明化,一排又一排大型酶解罐、发酵罐映入眼帘,全自动酵素发酵生产线蔚为壮观。自主产权菌BXM2已成为企业主要发酵菌株。桑葚、猕猴桃、柠檬、西梅、火麻仁等经过清洗、破碎、打浆、发酵、灌装等系列工序,就能转化成高价值的发酵营养品。 数据显示,围绕BXM2开发的多款草本及水果发酵品已实现量产,至今已累计生产超4000万袋(瓶)。目前,BXM2已经完全实现对进口菌种的替代,广泛应用于水果、蔬菜、谷类、中草药等发酵。立足中国市场,该公司生产的胶原蛋白肽系列、酵素液、发酵果酒等产品出口美国、欧盟、日本、澳大利亚等国家和地区。 在这里,产研一体融合的速度越来越快。“我们已开发出高活力高稳定BXM2菌制剂,菌剂厂房和生产线正建设中,计划投入5000万元,年底投产上市。”赵大洲说,围绕益生菌产业链的深度研发,公司正着手制备BXM2冻干粉,争取每克冻干粉含5000亿个BXM2菌,预计2023年水果草本加工量5000吨左右,产值可达到1亿元。 这只是一个缩影。围绕我省产业的发展布局和需要,福建省农业科学院与企业携手,不断梳理产业发展急需的关键技术,推动产研深度融合,聚力破解技术瓶颈,使科技创新这一核心驱动力从关键变量转化为高质量发展的最大增量。 记者手记 产研深融,需汇聚创新要素 “一株植物乳杆菌及其应用”专利,是科研人员在田间地头发现问题,在实验室探索出相关方案,并将科研成果商业化落地,实现产研融合的生动范本。 随着越来越多科研人员与企业家携手布局,福建产研融合正在持续加速。科研人员走向产业端,试图实现理论落地,而企业研发有了更多的主动权,布局源头创新,实现新的突破。 产研融合,既是优势互补,也是强强联手,无疑将实现双方从学术到市场、从原料研发到产品生产等环节合作的全面落地。 但也要意识到,要达成产研融合的效果,非一朝一夕之功。科学家、企业家“破圈”,政府必须是参与者、服务者、引导者,从管理制度、分配方式、引导政策、政府投入、组织模式等方面构建制度规则。一方面,要继续创新机制搭建平台,加强产研主体双向引导,让技术与产业无缝对接;另一方面,及时洞悉市场需求和产业需求,构建促进科技成果转化的考评体系、科技成果转化收益分配机制等政策体系,通过制度建设使产研融合更加顺畅。 产研融合也是技术、人才、资金、信息等创新资源重新配置和动态优化的过程。期待通过聚集相关专业优势高校院所、链主企业、产业资本、政府政策支持等创新要素,切实推动产研高效对接、深度融合,让更多科研成果走向市场,让更多“卡脖子”问题得到解决。 |